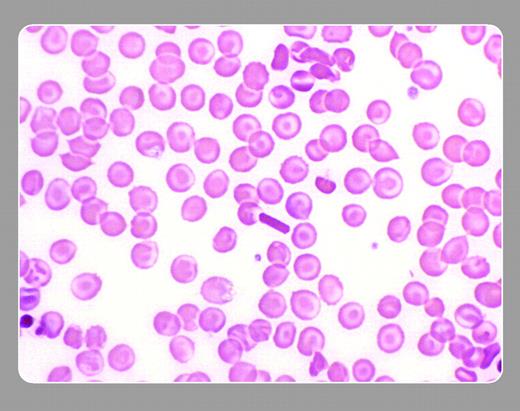
John Lazarchick, Medical University of South Carolina

Peripheral smear from a patient with homozygous hemoglobin C disease. A large rhomboid hemoglobin C crystal is present in the center of the image. Numerous target cells characteristic of this hemoglobinopathy are present. A dense microspherocyte can be seen in the lower left.FIG1
Many Blood Work images are provided by the ASH IMAGE BANK, a reference and teaching tool that is continually updated with new atlas images and images of case studies. For more information or to contribute to the Image Bank, visit www.ashimagebank.org.
Copyright © 2005 by The American Society of Hematology
2005
John Lazarchick, Medical University of South Carolina